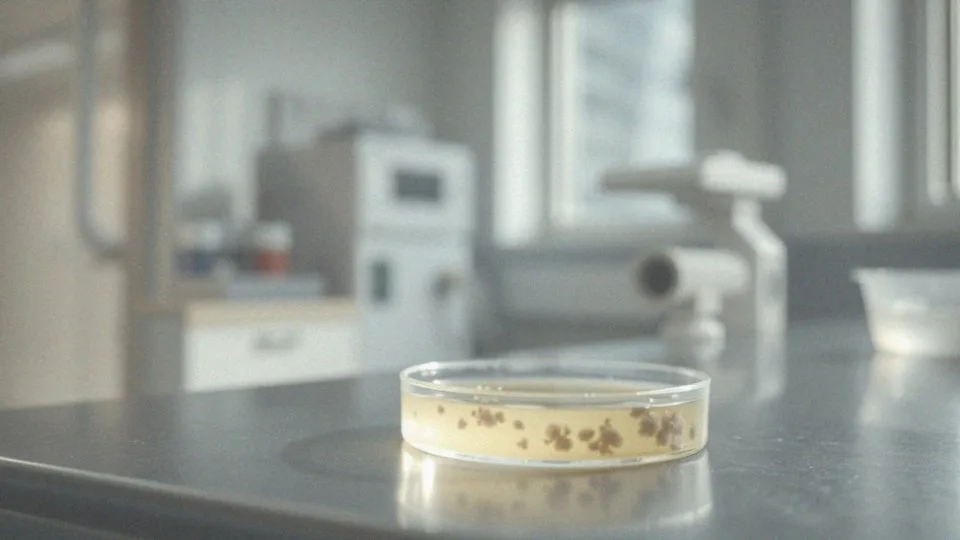

Spis treści
Co to jest posiew moczu u noworodka?
Posiew moczu u noworodków jest istotnym badaniem mikrobiologicznym, które pozwala na ocenę funkcjonowania układu moczowego. Jego głównym celem jest identyfikacja bakterii oraz grzybów w próbkach moczu.
Takie badania mają kluczowe znaczenie, ponieważ mogą wskazywać na obecność infekcji układu moczowego, które u noworodków bywają szczególnie niebezpieczne. W trakcie posiewu pobiera się próbkę moczu, a następnie analizuje ją w laboratorium. Wynik badania może być:
- pozytywny, co oznacza wykrycie drobnoustrojów,
- negatywny, co sugeruje ich brak.
Noworodki narażone są na większe ryzyko zakażeń, dlatego ważne jest, aby na wszelkie niepokojące symptomy reagować szybko. Zlecane jest wykonanie posiewu w sytuacjach podejrzenia infekcji, na przykład przy:
- pojawieniu się gorączki,
- nadmiernej drażliwości.
Lekarz będzie interpretował wyniki posiewu, co ma kluczowy wpływ na dalsze kroki diagnostyczne oraz terapeutyczne. Regularne badania moczu są niezbędne, ponieważ przyczyniają się do wczesnego wykrywania problemów zdrowotnych, co jest szczególnie ważne w przypadku noworodków, które wymagają natychmiastowej interwencji medycznej.
Dlaczego wykonuje się posiew moczu u noworodka?

Posiew moczu u noworodków ma na celu identyfikację ewentualnych zakażeń układu moczowego. To badanie staje się szczególnie istotne w sytuacjach, gdy:
- wyniki ogólnej analizy moczu budzą wątpliwości,
- pojawiają się objawy kliniczne, takie jak gorączka,
- pojawia się nadmierna drażliwość.
Infekcje u najmłodszych mogą prowadzić do poważnych komplikacji, dlatego szybkie postawienie diagnozy jest niezwykle ważne. Na przykład, w przypadku wystąpienia żółtaczki lub innych niepokojących symptomów, lekarze często zlecają posiew moczu, aby zidentyfikować patogeny odpowiedzialne za infekcję. Ta metoda pozwala również na ocenę skuteczności stosowanego leczenia, co ma kluczowe znaczenie w opiece nad noworodkami. Dokładna analiza wyników posiewu moczu daje podstawy do określenia przyszłej terapii. Dodatkowo, regularne przeprowadzanie tego badania wspiera wczesne wykrywanie oraz leczenie ewentualnych zakażeń, co jest niezbędne dla zapewnienia zdrowia tych delikatnych pacjentów.
Jakie są wskazania do przeprowadzenia badania posiewu moczu?
Wskazania do przeprowadzenia badania posiewu moczu są zróżnicowane i obejmują szereg objawów oraz stanów klinicznych. Przede wszystkim warto zwrócić uwagę na dzieci poniżej 2. roku życia, u których występuje gorączka o nieustalonej przyczynie – w takich przypadkach zaleca się wykonanie posiewu. Inne istotne przesłanki to:
- częstomocz,
- ból lub pieczenie towarzyszące oddawaniu moczu,
- podejrzenie schorzeń nerek, takich jak leukocyturia, krwiomocz czy obecność białka w moczu.
Dodatkowo, u noworodków z przedłużającą się żółtaczką posiew może być istotny, ponieważ może sugerować infekcję w obrębie układu moczowego. Ponadto, u osób z nawracającymi zakażeniami dróg moczowych regularne badania moczu są niezbędne, aby wykluczyć obecność niepożądanych drobnoustrojów. Szybka diagnoza w takich sytuacjach jest kluczowa, ponieważ umożliwia skuteczniejsze leczenie, co ma ogromne znaczenie dla zdrowia najmłodszych pacjentów.
Jakie objawy wskazują na potrzebę badania moczu u niemowlęcia?
Objawy mogące sugerować konieczność wykonania badania moczu u niemowląt są zróżnicowane i nierzadko niejednoznaczne. Często zauważaną oznaką jest gorączka, której przyczyna nie jest jasna, co może sugerować infekcję. Innym istotnym objawem jest brak apetytu, który może być wynikiem odczuwanego dyskomfortu. Wymioty, szczególnie związane z stanami zapalnymi, także powinny zwrócić naszą uwagę. Warto być czujnym na drażliwość maluszka oraz na zmiany w zapachu moczu – ich intensywny, nieprzyjemny aromat, jak również obecność krwi lub ropy, to poważne sygnały alarmowe. U noworodków i niemowląt przedłużająca się żółtaczka często może wskazywać na dodatkowe problemy zdrowotne, w tym na infekcje układu moczowego.
Jeśli zaobserwujesz którykolwiek z tych objawów, niezwłocznie skontaktuj się z pediatrą lub nefrologiem. Dokładne badania, w tym analiza moczu, są kluczowe. Szybka reakcja zwiększa szanse na wczesne zdiagnozowanie oraz skuteczne leczenie potencjalnych problemów zdrowotnych.
Jakie są metody pobierania moczu u noworodków?

Prawidłowe pobieranie moczu u noworodków odgrywa istotną rolę w diagnozowaniu infekcji układu moczowego. Istnieje kilka sposobów na uzyskanie próbki moczu. Najczęściej stosowaną metodą jest standardowe oddawanie moczu do jałowego pojemnika, które można wykorzystać, gdy noworodek jest w stanie samodzielnie się załatwić.
Jeśli ta opcja nie jest możliwa, alternatywą są woreczki moczowe, które można umieścić na sromie. Choć nie są one odpowiednie do posiewu, umożliwiają przeprowadzenie analizy ogólnej.
W przypadku podejrzenia infekcji, kluczowym wyborem staje się cewnikowanie pęcherza moczowego. To bardziej skomplikowana, inwazyjna procedura, stosowana kiedy inne metody nie przynoszą rezultatów. W najtrudniejszych sytuacjach zastosowanie znajduje nakłucie nadłonowe pęcherza, które uważane jest za najbardziej niezawodny sposób na pozyskanie próbki moczu.
Ostateczny dobór metody zależy od wieku malucha, jego stanu zdrowia oraz celu badania. Cały proces powinien być przeprowadzony zgodnie z zasadami aseptyki, co jest kluczowe dla zminimalizowania ryzyka wystąpienia zakażeń wtórnych.
Jak przygotować się do pobrania moczu do posiewu?
Przygotowanie do pobrania moczu w celu przeprowadzenia posiewu ma kluczowe znaczenie dla uzyskania rzetelnych rezultatów. Na początku warto:
- starannie umyć okolice cewki moczowej oraz sromu u niemowlęcia,
- użyć mydła antybakteryjnego albo płynu przeznaczonego do higieny intymnej,
- osuszyć skórę jałowym gazikiem.
Aby pobrać mocz, niezbędny będzie jałowy pojemnik lub specjalny zestaw dostępny w aptece. Zaleca się przeprowadzenie zbiórki rano, w trakcie pierwszej mikcji, co zwiększa szanse na uzyskanie odpowiedniej próbki do analizy. Ważne jest także, aby unikać wszelkich środków dezynfekujących opartych na alkoholu, ponieważ mogą one wpływać na wyniki badania. Przestrzeganie zasad higieny podczas tego procesu jest kluczowe, aby uniknąć skażenia próbki, co jest niezbędne do prawidłowej interpretacji wyników posiewu moczu.
Jak pobrać mocz do analizy u noworodka?
Pobieranie moczu od noworodka do analizy wymaga szczególnej uwagi oraz przestrzegania zasad higieny. Proces ten rozpoczyna się od:
- starannego umycia i osuszenia okolic narządów płciowych malucha,
- skorzystania z mydła antybakteryjnego oraz jałowego gazika, co znacznie redukuje ryzyko zanieczyszczenia próbki.
Gdy obszar jest już czysty, można przystąpić do pobrania moczu. Często stosuje się do tego specjalny woreczek, który przylepia się do sromu. Kluczowe jest, by woreczek był prawidłowo umiejscowiony i regularnie sprawdzany. Kiedy dziecko odda mocz, należy natychmiast przelać zawartość do jałowego pojemnika. Jeśli jednak woreczek nie okazał się skuteczny, istnieje możliwość przeprowadzenia cewnikowania pęcherza moczowego; jest to bardziej inwazyjna metoda, więc wymaga szczególnej aseptyki. W wyjątkowych sytuacjach, aby uzyskać czystą próbkę, można rozważyć nakłucie nadłonowe pęcherza.
Zebrany mocz powinien być jak najszybciej dostarczony do laboratorium. Na wyniki badania posiewu moczu można czekać od 24 do 48 godzin. Właściwa technika pobierania moczu jest niezbędna, aby otrzymać rzetelne wyniki, co jest istotne podczas diagnozowania ewentualnych zakażeń u noworodków.
Jak długo czeka się na wyniki posiewu moczu?
Czas oczekiwania na wyniki badania moczu wynosi zazwyczaj od dwóch do pięciu dni roboczych. W laboratoriach próbki moczu są umieszczane na odpowiednich podłożach, co umożliwia rozwój bakterii. Po tym procesie następuje identyfikacja różnych gatunków drobnoustrojów. Kolejnym krokiem jest wykonanie antybiogramu, który pozwala ocenić, jak te mikroorganizmy reagują na antybiotyki. Warto jednak zauważyć, że w sytuacjach, gdy pojawiają się trudności z identyfikacją, czas oczekiwania może się wydłużyć. Precyzyjność analiz wykonanych przez laboratoria ma kluczowe znaczenie dla wdrożenia skutecznych metod leczenia. Dodatkowo, regularne kontrole i szybkie uzyskiwanie wyników są niezwykle istotne, zwłaszcza w przypadku noworodków, które są szczególnie podatne na infekcje układu moczowego.
Jakie bakterie najczęściej wykrywa posiew moczu?
Posiew moczu jest kluczowym badaniem, które umożliwia wykrywanie bakterii odpowiedzialnych za infekcje układu moczowego. Najczęściej spotykanym mikroorganizmem jest Escherichia coli (E. coli), który odpowiada za 80-90% przypadków tego rodzaju zakażeń. Inne bakterie, które można znaleźć w wynikach badania, to:
- Klebsiella pneumoniae,
- Proteus mirabilis,
- Enterococcus faecalis,
- Staphylococcus aureus.
Choć rzadziej, mogą również występować grzyby, takie jak Candida albicans. E. coli naturalnie występuje w jelicie grubym, a jej nadmiar w moczu bywa przyczyną poważnych problemów zdrowotnych. Zarówno Klebsiella pneumoniae, jak i Proteus mirabilis mogą prowadzić do zakażeń, zwłaszcza u osób o obniżonej odporności.
Dla noworodków, które są szczególnie narażone na komplikacje, identyfikacja tych patogenów jest niezwykle istotna. Infekcje dróg moczowych mogą wiązać się z długotrwałymi konsekwencjami zdrowotnymi, dlatego rzetelna diagnostyka oraz adekwatne leczenie są nieprzemijającą potrzebą. Lekarze często zalecają regularne monitorowanie wyników posiewu, co pozwala im na bieżąco oceniać skuteczność terapii oraz dostosowywać ją do indywidualnych potrzeb pacjentów.
Jakie są normy w badaniach moczu u niemowląt?
Wyniki analiz moczu u niemowląt mają istotne znaczenie dla prawidłowej interpretacji stanu zdrowia malucha. W ogólnym badaniu moczu szczególnie istotne są wartości, które mówią o obecności leukocytów – ich ilość nie powinna przekraczać pięciu w polu widzenia. Również ważne jest, abyśmy nie zauważyli żadnych erytrocytów ani białka.
Odpowiedni ciężar właściwy moczu różni się w zależności od wieku oraz poziomu nawodnienia dziecka. Prawidłowe pH moczu u niemowląt mieści się w zakresie od 5 do 7. Gdy przeprowadzamy posiew moczu, normą jest brak wzrostu bakterii bądź ich obecność w ilości nieprzekraczającej 10^3 CFU/ml, co świadczy o braku zakażenia układu moczowego.
W sytuacjach, które budzą wątpliwości lub pojawią się objawy niepokojące, warto zwrócić się o pomoc do pediatry lub nefrologa. Specjalista pomoże w prawidłowej ocenie wyników. Wszelkie nieprawidłowości mogą sygnalizować potrzebę dalszych badań i leczenia, co jest niezwykle ważne dla zdrowia najmłodszych pacjentów.
Jak interpretować wyniki posiewu moczu u noworodka?
Interpretacja wyników posiewu moczu u noworodków odgrywa zasadniczą rolę w diagnozowaniu infekcji układu moczowego. Badania te mogą dawać wyniki pozytywne lub negatywne. W przypadku wyniku negatywnego świadczy to o braku bakterii lub ich minimalnej ilości – poniżej 10^3 CFU/ml. Taki rezultat zazwyczaj budzi optymizm. Natomiast pozytywny wynik, wskazujący na liczbę bakterii wyższą niż 10^5 CFU/ml, potwierdza istnienie zakażenia.
Ważne jest również zidentyfikowanie gatunku bakterii. Na przykład, Escherichia coli jest często odpowiedzialna za powszechne infekcje, podczas gdy inne drobnoustroje, jak Klebsiella pneumoniae, mogą wymagać odmiennych metod leczenia. Aby trafnie ocenić wynik posiewu moczu, należy również uwzględnić ogólne wyniki badania moczu oraz stan zdrowia noworodka.
Objawy takie jak:
- gorączka,
- drażliwość,
- znaczny spadek apetytu.
mogą sugerować konieczność dalszych badań. Analizę wyników powinien zawsze przeprowadzać wykwalifikowany specjalista, który zaplanuje odpowiednie kroki w leczeniu. Rzetelna interpretacja wyników jest kluczowa dla skutecznej diagnostyki i leczenia zakażeń, zwłaszcza u najmłodszych pacjentów.
Jakie są różnice między wynikiem dodatnim a ujemnym w posiewie moczu?
Dodatni wynik w posiewie moczu wskazuje na obecność bakterii w liczbie przekraczającej 10^5 CFU/ml, co sugeruje aktywne zakażenie układu moczowego. Taki rezultat oznacza, że organizm zmaga się z infekcją, co wymaga dalszej diagnostyki oraz ewentualnej terapii. Z kolei wynik ujemny sugeruje brak bakterii lub ich minimalny poziom, poniżej 10^3 CFU/ml, co zazwyczaj wskazuje na brak aktywnego zakażenia. Różnice te mają kluczowe znaczenie dla postawienia diagnozy.
Na przykład, w przypadku wystąpienia objawów klinicznych, takich jak:
- gorączka,
- drażliwość.
Pozytywny wynik posiewu może wymagać wprowadzenia antybiotyków. Natomiast wynik negatywny może nakłonić lekarza do dalszego badania, aby ustalić źródło objawów. Szczególnie ważna jest interpretacja wyników posiewu moczu u noworodków, gdzie istotne jest uwzględnienie nie tylko liczby bakterii, ale także ogólnego stanu zdrowia pacjenta oraz obserwowanych symptomów. Zrozumienie różnic między wynikami dodatnimi a ujemnymi jest kluczowe dla skutecznego leczenia zakażeń układu moczowego.
Co może oznaczać dodatni wynik posiewu moczu?

Dodatni wynik posiewu moczu u noworodka może wskazywać na obecność bakterii, co w wielu przypadkach sugeruje zakażenie układu moczowego. Taki rezultat może oznaczać zarówno:
- objawowe zakażenie,
- bakteriurię bezobjawową.
W takiej sytuacji kluczowe jest przeprowadzenie analizy ogólnej moczu oraz ocena towarzyszących objawów klinicznych, takich jak:
- gorączka,
- zwiększona drażliwość dziecka.
Jeśli diagnostyka przynosi dodatnie wyniki, konieczna jest decyzja lekarza pediatry lub nefrologa co do kolejnych kroków w leczeniu. Warto również pamiętać, że wyniki fałszywie dodatnie mogą wystąpić, na przykład, na skutek niewłaściwego pobrania próbki, co może prowadzić do niepotrzebnych i stresujących dla rodziców interwencji. Dlatego wyniki posiewu powinny być zawsze interpretowane w kontekście objawów oraz innych badań. Szybki czas diagnozy i adekwatne leczenie są niezbędne, aby zminimalizować ryzyko powikłań związanych z zakażeniami układu moczowego u noworodków.
Kiedy należy zgłosić się do lekarza po uzyskaniu wyników badania moczu?
Po otrzymaniu wyników badań moczu, warto umówić się na konsultację z lekarzem. To szczególnie ważne, gdy zauważamy niepokojące objawy. Do takich sygnałów mogą należeć:
- gorączka,
- ból lub pieczenie przy oddawaniu moczu,
- silne parcie na pęcherz,
- częste oddawanie moczu,
- zmiana koloru moczu,
- jego nieprzyjemny zapach.
Objawy te mogą wskazywać na infekcję układu moczowego, co z pewnością wymaga szybkiej interwencji. Jeśli wynik posiewu moczu wskazuje na infekcję, konieczne jest wykonanie dalszych badań. W takiej sytuacji lekarz może również zalecić stosowanie antybiotyków. To wykwalifikowany specjalista podejmie decyzje o dalszych krokach w terapii, a jego priorytetem będzie troska o zdrowie pacjenta.
Należy pamiętać, że wyniki badań nie zawsze są jednoznaczne, dlatego warto powierzyć ich interpretację profesjonaliście, który zadba o odpowiednią opiekę oraz zaproponuje skuteczne leczenie. Regularne badania moczu odgrywają kluczową rolę w monitorowaniu stanu zdrowia, szczególnie u noworodków, które mogą być bardziej podatne na zakażenia układu moczowego. Dlatego tak istotne są okresowe analizy, które pozwalają na wczesne wykrywanie ewentualnych problemów.
Co zrobić w przypadku niepokojących wyników posiewu moczu?
Kiedy wyniki posiewu moczu budzą obawy, niezwykle istotne jest, aby jak najszybciej zgłosić się do pediatry lub nefrologa. Taki specjalista dokładnie oceni zdrowie dziecka i, w razie potrzeby, może zlecić dodatkowe badania. Można tutaj wymienić takie procedury jak:
- USG jamy brzusznej,
- cystografia mikcyjna,
- renoscyntygrafia DMSA.
Dzięki nim możliwe będzie ustalenie źródła zakażenia. Należy także pamiętać, jak ważne jest stałe monitorowanie stanu noworodka oraz szczegółowe przestrzeganie zaleceń medycznych. W sytuacji, gdy posiew wskazuje na obecność bakterii w ilości przekraczającej 10^5 CFU/ml, może być konieczna terapia antybiotykowa. Ruch w tym kierunku ma kluczowe znaczenie, ponieważ zbyt długie oczekiwanie może prowadzić do poważnych komplikacji zdrowotnych. Infekcje układu moczowego u najmłodszych mogą prowadzić do długotrwałych skutków.
Dodatkowo, regularne kontrole są nieodzowne. Dzięki bieżącej ocenie skuteczności terapii istnieje możliwość dostosowania leczenia do unikalnych potrzeb pacjenta. Każda nieprawidłowość w wynikach powinna być dokładnie analizowana w kontekście objawów klinicznych oraz ogólnego stanu zdrowia dziecka. Taki szczegółowy przegląd zwiększa szansę na skuteczne i promptowe leczenie.
Jakie czynniki ryzyka mogą wpłynąć na wyniki posiewu moczu?
Czynniki ryzyka, które mają wpływ na wyniki posiewu moczu, są zróżnicowane i odgrywają istotną rolę w diagnozowaniu zakażeń układu moczowego. Należy uwzględnić:
- niewłaściwe pobranie próbki moczu, co może prowadzić do fałszywych wyników, zarówno dodatnich, jak i ujemnych,
- zanieczyszczenie próbki, co utrudnia ocenę,
- stosowanie antybiotyków przed pobraniem moczu, które może skutkować wynikami fałszywie ujemnymi,
- obecność wad wrodzonych, takich jak refluks pęcherzowo-moczowodowy,
- czynniki metaboliczne, takie jak cukrzyca, które osłabiają odporność organizmu,
- odwodnienie, które wpływa na koncentrację moczu,
- różnice wiekowe i płciowe noworodków, które mogą wpływać na ryzyko infekcji.
Zrozumienie wszystkich tych czynników jest niezbędne dla skutecznego diagnozowania oraz odpowiedniego leczenia.
Jakie są skutki zakażeń układu moczowego u noworodków?
Zakażenia układu moczowego u noworodków mogą prowadzić do poważnych i długofalowych problemów zdrowotnych. Na przykład, często skutkują ostrym odmiedniczkowym zapaleniem nerek, co z kolei może prowadzić do uszkodzenia oraz bliznowacenia tego organu. Taki stan rzeczy zwiększa ryzyko wystąpienia:
- nadciśnienia tętniczego,
- przewlekłej niewydolności nerek,
- nawracających infekcji,
- sepsy.
Dodatkowo, te infekcje mogą prowadzić do sepsy, stanu zagrażającego życiu, który wymaga natychmiastowej interwencji medycznej. Dlatego tak ważne jest wczesne rozpoznanie oraz skuteczne leczenie zakażeń, aby uniknąć groźnych powikłań. Regularne badania moczu i dokładna obserwacja objawów mają kluczowe znaczenie dla przyszłej sprawności nerek. W związku z wysokim ryzykiem powikłań, lekarze rekomendują szybkie działanie w przypadku zauważenia jakichkolwiek symptomów infekcji.
Jak wyglądają badania na obecność bakterii w moczu?

Badania mające na celu wykrycie bakterii w moczu są niezwykle ważne w diagnostyce zakażeń układu moczowego, szczególnie w przypadku noworodków. W ich skład wchodzi zarówno badanie ogólne moczu, jak i posiew.
Proces badania ogólnego obejmuje analizę mikroskopową próbki, gdzie szuka się:
- leukocytów,
- erytrocytów,
- oraz innych składników, mogących świadczyć o obecności infekcji.
Na przykład, znaczny wzrost liczby leukocytów może sugerować stan zapalny w organizmie. Posiew moczu z kolei to test mikrobiologiczny, który umożliwia namnażanie bakterii. Próbka jest umieszczana na specjalnych pożywkach, co sprzyja ich wzrostowi. Po kilku dniach laboratoria dokonują analizy, identyfikując obecne drobnoustroje. Dodatkowo, wykonuje się antybiogram, który bada wrażliwość wykrytych bakterii na różne leki przeciwbakteryjne. Mikroskopowa ocena osadu moczu również pozwala na określenie obecności bakterii oraz komórek zapalnych.
Wyniki posiewu mogą być zarówno pozytywne, jak i negatywne. Pozytywny rezultat wskazuje na obecność bakterii w liczbie przekraczającej 10^5 CFU/ml, co wymaga podjęcia interwencji medycznej. Z kolei negatywny wynik, oznaczający brak bakterii lub ich minimalną ilość poniżej 10^3 CFU/ml, sugeruje, że nie ma aktywnego zakażenia.
Regularne przeprowadzanie tych badań, zwłaszcza u noworodków, odgrywa kluczową rolę w wczesnym wykrywaniu ewentualnych infekcji, co jest niezbędne dla ich prawidłowego rozwoju.